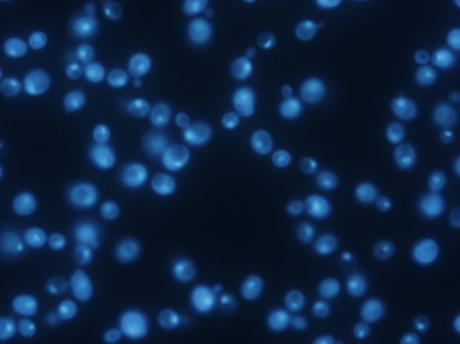
Cómo cuantificar cualquier biomolécula que contenga azufre

Hoy os voy a presentar un método universal para el bioanálisis del azufre y sus compuestos, es decir, un nuevo método de análisis químico que permite cuantificar cualquier biomolécula que contenga azufre en su estructura, lo que incluye aminoácidos, péptidos y proteínas, fármacos, drogas y un largo etcétera. Allá voy:
El azufre (S) es un elemento traza esencial para todos los organismos vivos y está presente en multitud de compuestos biológicamente importantes, como en los aminoácidos azufrados taurina y homocisteína, en las vitaminas B1 (tiamina) y B7 (biotina), la coenzima A, etc.
La presencia del azufre es particularmente relevante en los aminoácidos proteinogénicos cisteína y metionina, es decir, en dos aminoácidos del exclusivo grupo de veinte que pueden participar en la formación de proteínas. Por ello, aunque la abundancia de la cisteína y la metionina en las proteínas no es muy elevada, sí forman parte de la gran mayoría de ellas. De hecho, estos dos aminoácidos juntos, exhiben una abundancia próxima al 3-4%, lo que significa que estadísticamente todos los péptidos/proteínas con una longitud de al menos 30 residuos de aminoácidos, contienen azufre. Por tanto, la determinación de azufre se podría utilizar como una herramienta genérica para la detección y cuantificación de la mayoría de péptidos y proteínas.
El empleo de isótopos de azufre en Química Analítica no es ninguna novedad. Como dato curioso, se conocen al menos 25 isótopos de azufre, tanto estables como radiactivos, la mayoría de los cuales han sido creados artificialmente. Casi todos los isótopos de azufre radiactivos (naturales o artificiales) poseen vidas medias del orden de segundos o incluso milisegundos, lo que limita enormemente su aplicabilidad analítica. Tradicionalmente, los estudios de metabolismo con trazadores de azufre se han llevado a cabo utilizando el isótopo radiactivo natural de azufre-35 (35S), con una vida media de 87 días. Entre sus aplicaciones se incluyen la mayoría de estudios fundamentales del metabolismo básico de azufre y sus aminoácidos, estudios de síntesis y degradación de proteínas (recambio proteico) y estudios farmacocinéticos y del metabolismo de drogas y medicamentos que contienen azufre en su estructura, por citar algunas áreas de interés. En este punto, me gustaría destacar que resultaría realmente innovador disponer de una metodología que permitiera poder estudiar el metabolismo del azufre evitando los riesgos derivados de la exposición a la radiación. Esto sería posible empleando isótopos estables enriquecidos de azufre. Únicamente cuatro de los isótopos naturales de azufre son estables (32S, 33S, 34S y 36S). El isótopo mayoritario es el azufre-32 con una abundancia del 94,93%, siendo destacable la baja abundancia isotópica que presentan el resto de isótopos estables: 33S (0,76%), 34S (4,29%) y 36S (0,02%), lo que los hace muy adecuados para su uso como trazadores (compuestos idénticos desde el punto de vista químico y funcional al compuesto natural, pero que pueden ser detectados específicamente por técnicas de espectrometría de masas).

En los últimos años, la creciente popularidad de la espectrometría de masas con fuente de plasma de acoplamiento inductivo, conocida como ICP-MS por sus siglas en inglés, ha acelerado el uso de isótopos estables para estudios de metabolismo. El empleo del ICP-MS como técnica de análisis para este tipo de estudios, se explica atendiendo a sus excelentes características como detector específico elemental, incluyendo: extremada sensibilidad, amplios intervalos lineales y la capacidad de medición simultánea de varios elementos y sus isótopos. Por todo ello, no es de extrañar, que en la actualidad el ICP-MS sea la técnica más utilizada como sistema de detección en las metodologías híbridas utilizadas para el análisis de especiación elemental, basadas en el acoplamiento de una técnica de separación poderosa (por ejemplo HPLC) con la detección por ICP-MS, lo que permite la determinación de compuestos que contengan o tengan asociado uno o varios heteroátomos medibles por ICP-MS (entendiendo por heteroátomo en un compuesto orgánico cualquier elemento distinto de C, O, H y N).
Con estos antecedentes, nuestras investigaciones han sido pioneras en la detección y determinación selectiva de aminoácidos, péptidos y proteínas en muestras de interés biológico a través de su contenido en azufre mediante la metodología híbrida HPLC-ICP-MS. En este sentido, los trazadores estables enriquecidos isotópicamente, pueden abrir nuevas puertas a la investigación del metabolismo de los elementos traza en los seres vivos, ya que permiten, por un lado, realizar un marcaje in vivo exento de los problemas derivados de la radiación y, por el otro, aplicar lo que se conoce como análisis por dilución isotópica, una herramienta analítica que proporciona información cuantitativa de máxima calidad.
Sin embargo, para el azufre, no resulta una tarea fácil disponer de los trazadores necesarios para realizar el marcaje in vivo. De hecho, si se pretende realizar estudios de metabolismo de péptidos y proteínas en mamíferos utilizando isótopos enriquecidos de azufre, se debe utilizar metionina, cisteína o péptidos o proteínas que las contengan marcadas con el isótopo de interés, dado que los mamíferos no son capaces de sintetizar estos aminoácidos y necesitan obtenerlos a través de la alimentación (por ejemplo: carnes, pescados, lácteos, huevos, frutos secos… todos ellos ricos en estos aminoácidos, bien como aminoácidos libres o bien como aminoácidos enlazados, fácilmente asequibles mediante la degradación de proteínas que los contengan). Afortunadamente para nuestros intereses, otros seres vivos como las levaduras sí pueden sintetizar compuestos orgánicos de azufre, ya que son capaces de reducir el sulfato inorgánico (que es la forma química más común en la que se encuentran los trazadores enriquecidos de azufre) a sulfuro y sintetizar a partir de él compuestos organoazufrados. Particularmente, la levadura Saccharomyces cerevisiae es una elección ventajosa debido a las elevadas tasas de crecimiento celular que puede alcanzar y a su inocuidad, al estar clasificado como microorganismo seguro para la salud por la agencia de alimentos y medicamentos (FDA) americana.

Por ello, en colaboración con el grupo de investigación de Biología Molecular y Biotecnología de Levaduras de la Universidad de Oviedo, se preparó levadura marcada isotópicamente con azufre-34. De esta manera, desarrollamos un protocolo de trabajo a partir de organismos vivos (biosíntesis), que permite tener acceso a una biomasa en la que todos sus aminoácidos, péptidos y proteínas se encuentran marcados con azufre-34, lo que sin duda por síntesis química presentaría una tremenda dificultad.
A continuación, se desarrolló un procedimiento basado en el empleo de trazadores múltiples de azufre para la caracterización de la levadura marcada con azufre-34. Este procedimiento analítico constituye la base de una nueva metodología cuantitativa para estudios de metabolismo de azufre. Asimismo, se podría establecer como una herramienta universal en el área emergente de la proteómica cuantitativa, ya que posibilita la cuantificación de péptidos y proteínas a través de su contenido en azufre, presente en los aminoácidos proteinogénicos cisteína y metionina. Finalmente, como prueba de concepto, se realizaron por primera vez estudios de metabolismo del azufre utilizando isótopos estables enriquecidos (no radiactivos). En concreto, se empleó levadura marcada con azufre-34 tanto en ensayos in vitro como en animales de laboratorio, evitando por tanto los riesgos derivados de la exposición a la radiación. Esta investigación os la presenté en el post anterior “el azufre de una levadura ayuda a seguir la pista a las proteínas animales”. Los resultados obtenidos nos indican que la metodología analítica propuesta se podría establecer como una estrategia alternativa en estudios del metabolismo de compuestos que contengan azufre en su estructura.
“Cómo cuantificar cualquier biomolécula que contenga azufre” se ha publicado este mes de julio como artículo de divulgación en la Revista de los Químicos de Asturias y León (Alquímicos). Puedes acceder a esta publicación haciendo clic aquí.



Espero que os haya gustado. ¡Un saludo!
Justo
«Ciencia Química en el siglo XXI» | Dr. Justo Giner
La entrada Cómo cuantificar cualquier biomolécula que contenga azufre se publicó primero en Dr. Justo Giner.
